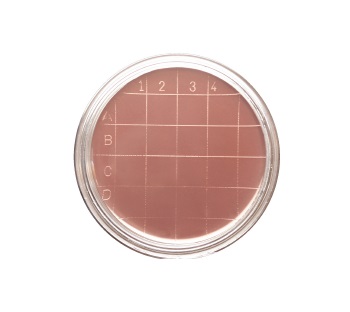

Cargando, por favor espere ...

Material para ensayos y análisis microbiológicos
| Código | Descripción | Disponibilidad | Precio 1x (€) |
Cantidad | Añadir | Precio 1x caja (€) |
Cantidad caja |
Añadir |
|---|---|---|---|---|---|---|---|---|
| 2135100818 | Baird Parker Agar, 20 plates, Ready culture media in 55 mm Rodac contact plates, individually packed, selective medium for Staphylococcus aureus isolation with inactivation of disinfectants, 20 cajas, LIOFILCHEM® | 5/12 días | 714,84 | 1 | Consultar | |||
| 2135100819 | Baird Parker Agar + Neutralizing, 20 plates, Ready culture media in 55 mm Rodac contact plates, individually packed, selective medium for Staphylococcus aureus isolation with inactivation of disinfectants, LIOFILCHEM® | 5/12 días | 94,19 | 1 | 31,88 | 5 | ||
| 2135100820 | Cetrimide Agar, 20 plates, Ready culture media in 55 mm Rodac contact plates, individually packed, selective medium for Pseudomonas aeruginosa isolation, LIOFILCHEM® | 5/12 días | 92,81 | 1 | 30,50 | 5 | ||
| 2135100821 | Cetrimide Agar + Neutralizing, 20 plates, Ready culture media in 55 mm Rodac contact plates, individually packed, selective medium for Pseudomonas aeruginosa isolation with inactivation of disinfectants, 25 cajas, LIOFILCHEM® | 5/12 días | 525,09 | 1 | Consultar | |||
| 2135100822 | Chromatic™ Coli/Coliform, 20 plates 55 mm, Chromogenic culture media, Chromogenic selective medium for E. coli and coliforms isolation and count in foods and water, 50 cajas, LIOFILCHEM® | 5/12 días | 2.215,59 | 1 | Consultar | |||
| 2135100823 | Chromatic™ Coliform Agar ISO, 20 plates 55 mm, Chromogenic culture media, Chromogenic selective medium for E. coli and coliforms enumeration, especially suitable for waters with low bacterial count, according to ISO 9308-1:2020, 50 cajas, LIOFILCHEM® | 5/12 días | 1.611,84 | 1 | Consultar | |||
| 2135100824 | D/E Neutralizing + Penase, 20 plates, Ready culture media in 55 mm Rodac contact plates, individually packed, 20 cajas, LIOFILCHEM® | 5/12 días | Consultar | 1 | Consultar | |||
| 2135100825 | Endo Agar, 20 plates, Ready culture media in 55 mm Rodac contact plates, individually packed, 30 cajas, LIOFILCHEM® | 5/12 días | 618,24 | 1 | Consultar | |||
| 2135100826 | Legionella BCYE Agar, 20 plates, Ready culture media in 55 mm Rodac contact plates, individually packed, non-selective medium for Legionella spp. Isolation, LIOFILCHEM® | 5/12 días | 117,30 | 1 | 54,99 | 5 | ||
| 2135100827 | Legionella GVPC Agar, 20 plates, Ready culture media in 55 mm Rodac contact plates, individually packed, selective medium for Legionella spp. Isolation, LIOFILCHEM® | 5/12 días | 110,40 | 1 | 48,09 | 5 | ||
| 2135100828 | MacConkey Agar, 20 plates, Ready culture media in 55 mm Rodac contact plates, individually packed, selective medium for gram-negatives isolation, LIOFILCHEM® | 5/12 días | 92,81 | 1 | 30,50 | 5 | ||
| 2135100829 | Mannitol Salt Agar, 20 plates, Ready culture media in 55 mm Rodac contact plates, individually packed, selective medium for staphylococci isolation, LIOFILCHEM® | 5/12 días | 92,81 | 1 | 30,50 | 5 | ||
| 2135100830 | Microbial Content Test Agar + 1% Penase, Ready culture media in 55 mm Rodac contact plates, individually packed, LIOFILCHEM® | 5/12 días | 161,12 | 1 | 98,81 | 5 | ||
| 2135100831 | m-Faecal Coliform Agar, 20 plates, Ready culture media in 55 mm Rodac contact plates, individually packed, selective medium for fecal coliforms isolation and enumeration, LIOFILCHEM® | 5/12 días | 92,81 | 1 | 30,50 | 5 | ||
| 2135100832 | Plate Count Agar (PCA), 20 plates, Ready culture media in 55 mm Rodac contact plates, individually packed, medium for surfaces and air total bacterial count, LIOFILCHEM® | 5/12 días | 92,81 | 1 | 30,50 | 5 | ||
| 2135100833 | Plate Count Agar (PCA)+ Neutralizing, 20 plates, Ready culture media in 55 mm Rodac contact plates, individually packed, medium for surfaces total bacterial count with inactivation of disinfectants, LIOFILCHEM® | 5/12 días | 94,71 | 1 | 32,41 | 5 | ||
| 2135100834 | Plate Count Agar (PCA)+ Neutralizing, 20 plates, Ready culture media in 55 mm Rodac contact plates, packed in two piles of 10 plates, medium for surfaces total bacterial count with inactivation of disinfectants, LIOFILCHEM® | 5/12 días | 94,71 | 1 | 32,41 | 5 | ||
| 2135100835 | Plate Count Agar (PCA)+ Neutralizing (Irradiated), 20 plates, Ready culture media in 55 mm Rodac contact plates, individually packed, Medium for surfaces total bacterial count with inactivation of disinfectants, LIOFILCHEM® | 5/12 días | 110,40 | 1 | 48,09 | 5 | ||
| 2135100836 | Plate Count Agar (PCA)+ TTC + Neutralizing, 20 plates, Ready culture media in 55 mm Rodac contact plates, individually packed, Medium for surfaces total bacterial count with inactivation of disinfectants, LIOFILCHEM® | 5/12 días | 97,82 | 1 | 35,51 | 5 | ||
| 2135100837 | Plate Count Agar (PCA)+ TTC + Neutralizing, 20 plates, Ready culture media in 55 mm Rodac contact plates, packed in two piles of 10 plates, medium for surfaces total bacterial count with inactivation of disinfectants, 50 cajas, LIOFILCHEM® | 5/12 días | 1.241,31 | 1 | Consultar | |||
| 2135100838 | Rose Bengal Agar + CAF, 20 plates, Ready culture media in 55 mm Rodac contact plates, individually packed, Selective Medium for yeasts and moulds isolation and enumeration, LIOFILCHEM® | 5/12 días | 92,81 | 1 | 30,50 | 5 | ||
| 2135100839 | Rose Bengal Agar + CAF + Neutralizing, 20 plates, Ready culture media in 55 mm Rodac contact plates, individually packed, Selective Medium for yeasts and moulds isolation and enumeration, 50 cajas, LIOFILCHEM® | 5/12 días | 1.266,84 | 1 | Consultar | |||
| 2135100840 | R2 Agar, 20 plates, Ready culture media in 55 mm Rodac contact plates, individually packed, medium for heterotrophic microorganisms count in drinking water, 20 cajas, LIOFILCHEM® | 5/12 días | 532,13 | 1 | Consultar | |||
| 2135100841 | Sabouraud Dextrose Agar, 20 plates, Ready culture media in 55 mm Rodac contact plates, individually packed, medium for yeasts and moulds isolation, LIOFILCHEM® | 5/12 días | 92,81 | 1 | 30,50 | 5 | ||
| 2135100842 | Sabouraud Dextrose Agar + Lactamator 500 IU + Neutralizing (Irradiated), 20 plates, Ready culture media in 55 mm Rodac contact plates, individually packed, medium for yeasts and moulds isolation with inactivation of ?-lactam antibiotics and disinfectants, 40 cajas, LIOFILCHEM® | 5/12 días | 3.164,34 | 1 | Consultar | |||
| 2135100843 | Sabouraud Dextrose Agar + 0.1% Penase + Neutralizing (Irradiated), 20 plates, Ready culture media in 55 mm Rodac contact plates, individually packed, medium for yeasts and moulds isolation with inactivation of disinfectants and penicillins, 40 cajas, LIOFILCHEM® | 5/12 días | 2.474,34 | 1 | Consultar | |||
| 2135100844 | Sabouraud Agar + Neutralizing (Irradiated), 20 plates, Ready culture media in 55 mm Rodac contact plates, individually packed, medium for yeasts and moulds isolation with inactivation of disinfectants, LIOFILCHEM® | 5/12 días | 110,40 | 1 | 48,09 | 5 | ||
| 2135100845 | Sabouraud Agar + Neutralizing (Irradiated), 400 plates, Ready culture media in 55 mm Rodac contact plates, individually packed, medium for yeasts and moulds isolation with inactivation of disinfectants, LIOFILCHEM® | 5/12 días | 764,18 | 1 | 701,87 | 5 | ||
| 2135100846 | Sabouraud CAF Agar (Irradiated), 20 plates, Ready culture media in 55 mm Rodac contact plates, individually packed, selective medium for yeasts and moulds isolation, LIOFILCHEM® | 5/12 días | 94,71 | 1 | 32,41 | 5 | ||
| 2135100847 | Sabouraud CAF Agar + Neutralizing, 20 plates, Ready culture media in 55 mm Rodac contact plates, individually packed, selective medium for yeasts and moulds isolation with inactivation of disinfectants, LIOFILCHEM® | 5/12 días | 92,81 | 1 | 30,50 | 5 | ||
| 2135100848 | Sabouraud CAF Agar + Neutralizing (Irradiated), 20 plates, Ready culture media in 55 mm Rodac contact plates, individually packed, selective medium for yeasts and moulds isolation with inactivation of disinfectants, 30 cajas, LIOFILCHEM® | 5/12 días | 1.037,62 | 1 | Consultar | |||
| 2135100849 | Slanetz Bartley Agar + Neutralizing, 20 plates, Ready culture media in 55 mm Rodac contact plates, individually packed, selective medium for fecal streptococci enumeration and isolation with inactivation of disinfectants, LIOFILCHEM® | 5/12 días | 92,81 | 1 | 30,50 | 5 | ||
| 2135100850 | TSA Tryptic Soy Agar (Irradiated), 20 plates, Ready culture media in 55 mm Rodac contact plates, individually packed, medium for surfaces and air total bacterial count, LIOFILCHEM® | 5/12 días | 97,82 | 1 | 35,51 | 5 | ||
| 2135100851 | TSA Tryptic Soy Agar + Neutralizing (Irradiated), 20 plates, Ready culture media in 55 mm Rodac contact plates, individually packed, medium for surfaces and air total bacterial count with inactivation of disinfectants, LIOFILCHEM® | 5/12 días | 110,40 | 1 | 48,09 | 5 | ||
| 2135100852 | TSA Tryptic Soy Agar + Neutralizing (Irradiated), 400 plates, Ready culture media in 55 mm Rodac contact plates, individually packed, medium for surfaces and air total bacterial count with inactivation of disinfectants, LIOFILCHEM® | 5/12 días | 695,18 | 1 | 632,87 | 5 | ||
| 2135100853 | TSA Tryptic Soy Agar + 0.1% Penase + Neutralizing, 20 plates, Ready culture media in 55 mm Rodac contact plates, individually packed, medium for surfaces and air total bacterial count with inactivation of disinfectants penicillins, 30 cajas, LIOFILCHEM® | 5/12 días | 887,34 | 1 | Consultar | |||
| 2135100854 | TSA Tryptic Soy Agar + 0.1% Penase + Neutralizing (Irradiated), 20 plates, Ready culture media in 55 mm Rodac contact plates, individually packed, medium for surfaces and air total bacterial count with inactivation of disinfectants penicillins, 30 cajas, LIOFILCHEM® | 5/12 días | 1.249,59 | 1 | Consultar | |||
| 2135100855 | TSA Tryptic Soy Agar + Penase + Cephalosporinase + Neutralizing, 20 plates, Ready culture media in 55 mm Rodac contact plates, individually packed, medium for microbial detection with inactivation of ?-lactam antibiotics and disinfectants, 50 cajas, LIOFILCHEM® | 5/12 días | 2.474,34 | 1 | Consultar | |||
| 2135100856 | TSA Tryptic Soy Agar + Lactamator 500 UI + Neutralizing (Irradiated), 20 plates, Ready culture media in 55 mm Rodac contact plates, individually packed, irradiated medium for non fastidious bacteria growth with inactivation of ?-lactam antibiotics and disinfectants, 20 cajas, LIOFILCHEM® | 5/12 días | 1.266,84 | 1 | Consultar | |||
| 2135100857 | Violet Red Bile Glucose Agar, 20 plates, Ready culture media in 55 mm Rodac contact plates, individually packed, selective Medium for enterobacteria isolation and enumeration, LIOFILCHEM® | 5/12 días | 97,82 | 1 | 35,51 | 5 | ||
| 2135100858 | Violet Red Bile Lactose Agar, 20 plates, Ready culture media in 55 mm Rodac contact plates, individually packed, selective Medium for coliforms isolation and enumeration, LIOFILCHEM® | 5/12 días | 92,81 | 1 | 30,50 | 5 | ||
| 2135100859 | Violet Red Bile Glucose Agar + Neutralizing, 20 plates, Ready culture media in 55 mm Rodac contact plates, individually packed, selective Medium for Enterobacteriaceae isolation and enumeration with inactivation of disinfectants, LIOFILCHEM® | 5/12 días | 92,81 | 1 | 30,50 | 5 | ||
| 2135100860 | Violet Red Bile Lactose Agar + Neutralizing, 20 plates, Ready culture media in 55 mm Rodac contact plates, individually packed, selective Medium for coliforms isolation and enumeration with inactivation of disinfectants, LIOFILCHEM® | 5/12 días | 92,81 | 1 | 30,50 | 5 | ||
| 2135100861 | TSA Tryptic Soy Agar + Neutralizing (Irradiated), 20 plates, Ready culture media in 55 mm Rodac contact plates, packed in two piles of 10 plates, medium for surfaces and air total bacterial count with inactivation of disinfectants, 30 cajas, LIOFILCHEM® | 5/12 días | 1.197,84 | 1 | Consultar | |||
| 2135100862 | Violet Red Bile Glucose Agar (VRBG), 20 plates, Ready culture media in 55 mm Rodac contact plates, packed in two piles of 10 plates, selective medium for enterobacteria isolation and enumeration, 50 cajas, LIOFILCHEM® | 5/12 días | 990,84 | 1 | Consultar | |||
| 2135100863 | Violet Red Bile Lactose Agar, 20 plates, Ready culture media in 55 mm Rodac contact plates, packed in two piles of 10 plates, selective medium for coliforms isolation and enumeration, 50 cajas, LIOFILCHEM® | 5/12 días | 990,84 | 1 | Consultar | |||
| 2135100864 | Wort Agar, 20 plates, Ready culture media in 55 mm Rodac contact plates, individually packed, Medium for the cultivation, isolation and enumeration or enrichment of fungi, especially of yeasts, LIOFILCHEM® | 5/12 días | 94,88 | 1 | 32,57 | 5 |